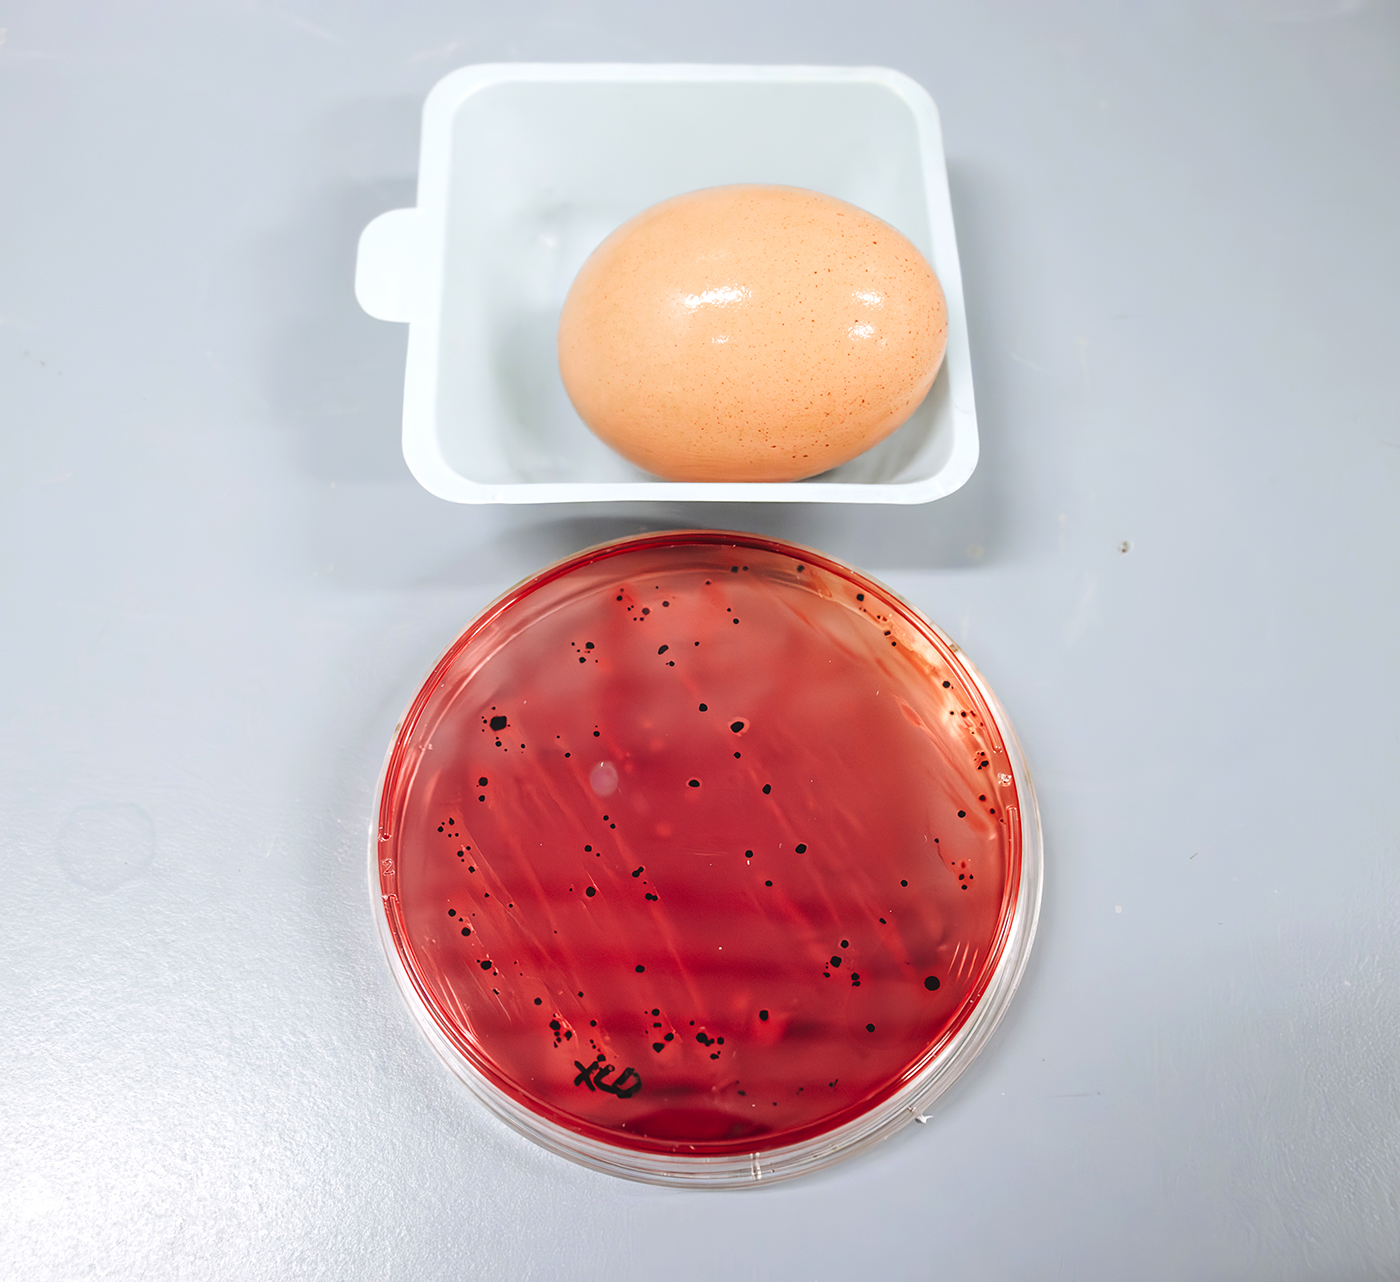

Analisi su
OLIO DI OLIVA
Per certificare la qualità dell'olio
extravergine d'oliva, il Lachimer effettua sia analisi chimico-fisiche che
sensoriale "panel test", ovvero la prova di assaggio: insieme, queste
due valutazioni attribuiscono a un olio una precisa categoria merceologica.
OLIVE
Al fianco dei produttori del
territorio e dell’ente di certificazione DOP per garantire il rispetto della
qualità delle olive da mensa, il Lachimer esegue le analisi sensoriali e
chimiche previste dal disciplinare di produzione della denominazione di origine
protetta “la bella della Daunia” e al regolamento regionale n.510/2006.
BEVANDE ALCOLICHE
Il Lachimer effettua analisi chimiche
per la determinazione del grado alcolico.
UOVA
Il Lachimer effettua analisi
microbiologiche sui prodotti alimentari esempio uova per la ricerca di
eventuali microrganismi patogeni, dannosi per la salute umana come la
salmonella.
TAMPONI SUPERFICIALI
In materia di salute e sicurezza deli
alimenti è fondamentale monitorare le condizioni igieniche delle superfici su
cui tali prodotti vengono manipolati come stabilito nel regolamento Europeo
2073/05. Il Lachimer effettua analisi microbiologichedi controllo al fine di verificare
che vengano rispettate le procedure igienico-sanitarie di ambienti di lavoro e
di conseguenza di confermare la validità del piano HACCP in uso.